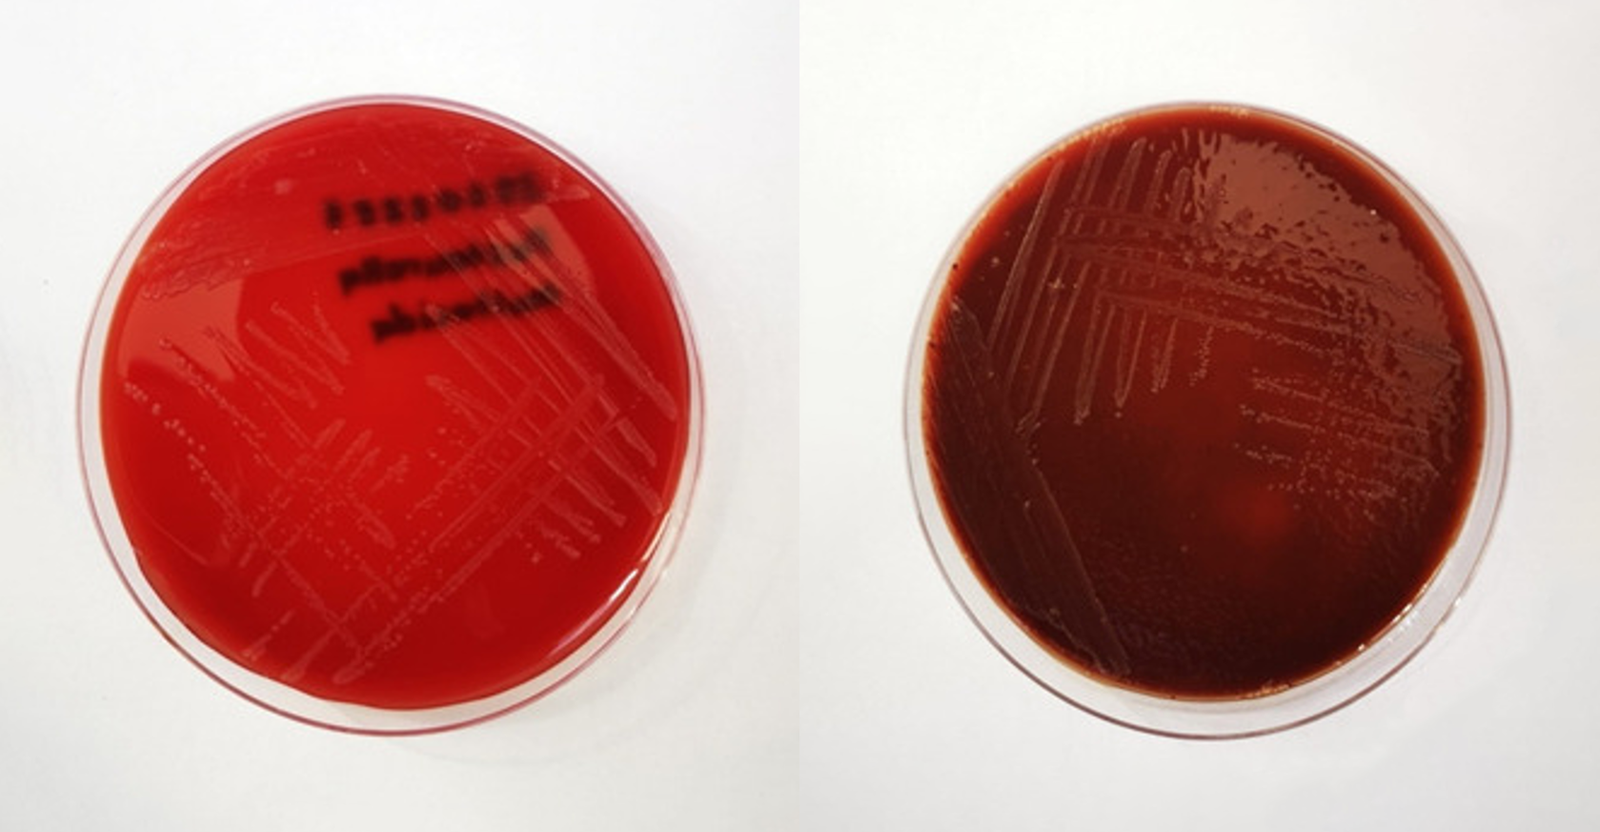

En Çok Okunanlar
Özet
Pasteurella multocida; hareketsiz, spor oluşturmayan, oksidaz, katalaz, indol-pozitif ve üreaz-negatif fakültatif anaerob Gram-negatif bir kokobasildir. Pasteurella infeksiyonlarında ısırma, tırmalama, yalama gibi hayvan temasları en önemli risk faktörleridir; ancak hayvanlarla temas öyküsü olmadan da görülebilir. Türkiye’de hayvan ısırıkları sonrası gelişen infeksiyonların seroprevelansı hakkında bilgiler kısıtlıdır. Bunun nedeni, olguların çoğunluğunun birinci basamak sağlık kuruluşlarına başvurması, söz konusu merkezlerde kültür yapılamamasından dolayı etkenin saptanamaması ve ampirik tedavi ile başarılı sonuçların elde edilmesidir. Bu olgu sunumunun amacı, Konya ili ve çevresinden ilk kez bildirilen hayvan ısırığı kaynaklı P. multocida’nın etken olduğu bir yumuşak doku infeksiyonunu incelemektir.
GİRİŞ
Pasteurella multocida ilk kez 1881 yılında Louis Pasteur tarafından infekte kuşlarda tespit edilmiştir (1); sıklıkla kedilerin, köpeklerin, bazı kuşların ağız florasında ve gastrointestinal sistemlerinde, nadiren de hayvan maruziyeti olan sağlıklı bireylerin nazofarenksinde görülmektedir (2). Pasteurella multocida; hareketsiz, spor oluşturmayan, oksidaz, katalaz, indol-pozitif ve üreaz- negatif fakültatif anaerob Gram-negatif bir kokobasildir (3,4). Çikolatamsı agar ve koyun kanlı agarda iyi ürer. Karbondioksitli ortamda 24 saatlik inkübasyon sonrası hemoliz oluşturmayan, mukoid veya mukoid olmayan, biyokimyasal özelliklerinden dolayı kötü kokuya sahip gri koloniler oluşturur. “Eosin methylen blue (EMB)” ve MacConkey agar gibi seçici besiyerlerinde üremez. Doku ve kandan yapılan preparatların boyanmasında bipolar mikroskobik görüntü tipiktir (4,5). Pasteurella multocida selülit, sepsis, menenjit gibi klinik tablolara yol açabilir.
Bu olgu sunumunun amacı, nadir izole edilen P. multocida’nın etken olduğu bir yumuşak doku infeksiyonunu incelemektir.
OLGU
Bilinen bir sağlık sorunu olmayan 44 aylık kız hasta, hastanemize başvurmadan 12 gün önce komşularına ait kuduz aşısı olmayan ev köpeği tarafından sol kolundan ısırılmıştı. Başvurduğu ilk acil serviste; sol kolundaki lezyonlar sütüre edilmiş, kuduz için aşılama protokolü başlatılmış ve ampirik amoksisilin-klavulanat tedavisi başlanmıştı. Oral amoksisilin-klavulanat tedavisinin, reçetede olduğu gibi 30 mg/kg/gün dozunda uygulandığı hastada, tedavinin altıncı gününde ateş, sol kol bölgesinde şişlik, kızarıklık ve yara yerinden kötü kokulu akıntı şikayetleri meydana gelmesi üzerine sütüre edilen yarası açılarak drene edilmiş ve pansuman yapılarak antibiyotik tedavisinin devamı önerilmişti.
Ateş şikayeti gerileyen fakat kolundaki akıntısı devam eden hasta hastanemize başvurdu. Genel durumu iyi olan hastanın ateşi 36.6 °C, nabzı 88/dk, tansiyonu 95/65 mm/Hg, solunum sayısı 26/dk saptanmış olup tüm değerler yaşına göre normal aralıktaydı. Başvuru esnasında sol kol medialde yaklaşık 3×0.5 cm çapında yoğun pürülan akıntılı, etrafı eritemli ve ciltten kabarık açık yaranın yanı sıra 5 cm ve 3 cm uzunluğunda sütüre edilmiş lezyonlar mevcuttu (Şekil 1). Laboratuvar tetkiklerinde; beyaz küre sayısı 8.39×103 İÜ/lt, nötrofil sayısı 2.35×103 İÜ/lt, nötrofil oranı %27.9, eritrosit sedimentasyon hızı 9 mm/saat ve C-reaktif protein (CRP) değeri 0.69 mg/lt olarak saptandı. Hastadan kan kültürü ve sürüntü yoluyla yara kültürü alındı. Ampirik intravenöz 200 mg/kg/gün dozunda ampisilin-sulbaktam ve 40 mg/kg/gün dozunda klindamisin tedavisi başlandı. Günlük olarak mupirosin içeren antibiyotikli kremle pansuman yapıldı. Yara kültürü örneğinden yapılan Gram boyamada, her alanda bol polimorf nüveli lökosit (PMNL) ve Gram-negatif kokobasiller görüldü. Yara kültürü örneği; koyun kanlı agar, EMB agar ve çikolatamsı agara ekilerek 18-24 saat 37°C’de inkübe edildi. İnkübasyon sonrasında kanlı ve çikolatamsı agarda üreme saptanırken EMB agarda üreme saptanmadı. Kanlı agarda gri renkte, hemoliz yapmayan koloniler görüldü. Kolonilerin; katalaz, oksidaz ve indol testleri pozitif saptanırken metil kırmızısı ve üreaz testleri negatif olarak tespit edildi. Bakteri tanımlaması ve antibiyotik duyarlılığı testi BD PhoenixTM 100 (Becton Dickinson, ABD) otomatize sistemi kullanılarak yapıldı ve P. multocida olarak tanımlandı (Şekil 2).
BD PhoenixTM 100 (Becton Dickinson, ABD) otomatize sistem ile yapılan antibiyotik duyarlılı testi sonucunda etken; penisilin, siprofloksasin, levofloksasin, ampisilin-sulbaktam, amoksisilin-klavulanik asit, sefotaksim ve trimethoprim-sulfametoksazole duyarlı olarak saptandı. Etken, ampisilin sulbaktama duyarlı olduğu için antibiyotik değişikliği yapılmadı ve intravenöz antibiyotik tedavisi dokuz güne tamamlandı. Ateşi ve aktif şikayeti olmayan, klinik ve laboratuvar parametreleri gerileyen hasta intravenöz tedavinin 10. gününde 80 mg/kg/gün dozunda oral ampisilin-sulbaktam ile toplam tedavi süresi 14 gün olacak şekilde taburcu edildi. Hastanın bir hafta sonra poliklinikte yapılan kontrol muayenesinde dikişleri alınan yara yerindeki akıntının tamamen kaybolduğu ve yara dudaklarının birleştiği görüldü.
İRDELEME
Pasteurella multocida infeksiyonu, hayvan ısırığı olmadan ortaya çıkabildiği gibi açık ve kısmen iyileşmiş yaraların kedi ve köpek tarafından yalanması sonucu da oluşabilir (6). Pasteurella multocida insanlarda selülit, pnömoni, menenjit, septik artrit, osteomyelit, tenosinovit, endokardit, peritonit ve sepsis gibi ciddi komplikasyonlara yol açabilir. Pasteurella multocida infeksiyonlarında ciddi komplikasyonların görülme sıklığı yeni doğanlarda, yaşlılarda ve immünosüpresyon durumlarında artmaktadır (7).
Ülkemizden bildirilen bir olgu sunumunda, 76 yaşındaki kadın hastada her iki bacağa sert bir cisim düşmesini takiben bacaklarda eritemli, akıntılı yaralar meydana gelmiştir. Hastaya klinik olarak nekrotizan yumuşak doku infeksiyonu tanısı konulmuştur. Hastadan yara kültürü ve kan kültürü alınıp ampirik antibiyotik tedavisi başlanmıştır. Kan kültüründe üreme olmayan hastanın yara kültüründe P. multocida üremiştir. Yara kültüründe P. multocida üremesi nedeniyle hasta, kedi, köpek teması ve ısırık öyküsü açısından ayrıntılı olarak sorgulandığında, hastanın evinde çok sayıda kedi beslediği öğrenilmiştir. Olgumuzda olduğu gibi, kutanöz bulguları tedavi sonrası gerilemeye başlamakla birlikte 15. günde dekompanse kalp yetmezliği nedeniyle hasta kaybedilmiştir (8).
Milani-Nejad ve arkadaşları (9) tarafından bildirilen bir olgu sunumunda ise 73 yaşındaki kadın hasta kolda döküntülü yara, ateş, bilinç değişikliği semptomlarıyla acil servise başvurmuştur. Sepsis ön tanısı konulan hastadan yara kültürü ve kan kültürü alınıp ampirik antibiyotik tedavisi başlanmıştır. Hastanın yara ve kan kültüründe P. multocida üremiştir. Dördüncü günde bilinci açılan hastanın anamnezi derinleştirildiğinde evde kedi beslediği öğrenilmiştir. Daha sonra klinik bulguları tekrar kötüleşen hasta nekrotizan fasiit ön tanısıyla acil ameliyata alınmıştır. Uygulanan tedaviler sonrasında hastadan alınan yara ve kan kültürlerinde üreme olmaması sonucu hasta oral antibiyotik tedavisi önerisiyle taburcu edilmiştir.
Hastamızda, uygun antibiyotik tedavisi ile nekrotizan fasiit, osteomyelit, sepsis gibi ciddi komplikasyonlar oluşmadan yumuşak doku infeksiyonu gerilemiştir. Pasteurella multocida infeksiyonları ölümcül komplikasyonlara yol açabileceği için evde hayvan besleyen, hayvan ısırığı öyküsü olan hastalarda herhangi bir yara infeksiyonu oluştuğunda P. multocida’nın etken olabileceği akılda tutulmalıdır. Yara yerinden kültür alınarak ampirik antibiyotik tedavisi başlanmalı, kullanılan antibiyotiğe direnç gelişirse antibiyotik duyarlılık testine göre uygun antibiyotik seçilmelidir. Ayrıca hastalarda tedavi için uygun antibiyotik dozunun uygulanması oldukça önemlidir. Sunduğumuz olgu sunumunda hastanın dış merkezdeki tedaviyi eksiksiz uygulamasına rağmen yara yeri infeksiyonunun gelişme nedeninin antibiyotik dozunun uygun olmamasından kaynaklı olduğunu düşünüyoruz. Pasteurella multocida olgularına ülkemizde nadiren rastlanmaktadır ve çalışmamız Konya ili ve çevresinden bildirilen ilk olgu sunumudur. Sonuç olarak, klinisyenler hayvan ısırığı veya teması olan yara infeksiyonlarında P. multocida’nın etken olabileceğini düşünerek ayırıcı tanıda dikkatli olmalıdır.
Hasta Onamı
Hastanın annesinden bilgilendirilmiş onam formu alınmıştır.
Danışman Değerlendirmesi
Bağımsız dış danışman.
Yazar Katkıları
Fikir/Kavram – B.E., H.G., M.Ö.; Tasarım – Me.Ö., M.D., Ö.M.A., M.Ö., H.G., B.E.; Denetleme – Me.Ö., M.D., Ö.M.A.; Veri Toplama ve/veya İşleme – B.E., H.G., M.Ö.; Analiz ve/veya Yorum – Me.Ö., B.E., M.D., Ö.M.A., M.Ö., H.G.; Literatür Taraması – B.E., H.G., M.Ö.; Makale Yazımı – B.E., H.G., Me.Ö., Ö.M.A., M.Ö., M.D.; Eleştirel İnceleme – B.E., H.G.
Çıkar Çatışması
Yazarlar herhangi bir çıkar çatışması bildirmemiştir.
Finansal Destek
Yazarlar finansal destek beyan etmemiştir.
Referanslar
- Harper M, Boyce JD, Adler B. Pasteurella multocida pathogenesis: 125 years after Pasteur. FEMS Microbiol Lett. 2006;265(1):1-10. [CrossRef]
- Lemenand O, Donnio P, Avril J. Pasteurelloses. EMC-Maladies Infectieuses. 2006;3(3):1-6. [CrossRef]
- Bradarić N, Milas I, Luksić B, Bojcić-Tonkić M, Karanović J. Erysipelas-like cellulitis with Pasteurella multocida bacteremia after a cat bite. Croat Med J. 2000;41(4):446-9.
- Procop GW, Church DL, Hall GS, et al. Koneman’s color atlas and textbook of diagnostic microbiology. 7th ed. Philadelphia: Wolters Kluwer Health, 2017: 509.
- Dziva F, Muhairwa AP, Bisgaard M, Christensen H. Diagnostic and typing options for investigating diseases associated with Pasteurella multocida. Vet Microbiol. 2008;128(1-2):1-22. [CrossRef]
- Mu H, Yang M, Zhang Y, et al. Pet-related Pasteurella multocida induced peritonitis in peritoneal dialysis: a case report and review of the literatures. BMC Nephrol. 2020;21(1):102. [CrossRef]
- Hasan J, Hug M. Pasteurella multocida [Internet]. Treasure Island (FL): StatPearls Publishing. [erişim 14 Kasım 2022]. https://www.ncbi.nlm.nih.gov/books/NBK557629/
- Ceyhan A, Kaya O, Başoğlu N, Tığlı A, Yıldırım M. [An uncommon case of necrotizing soft tissue infection caused by Pasteurella multocida]. Turkiye Klinikleri J Med Sci. 2010;30(1):439-42. [CrossRef]
- Milani-Nejad N, Tyler K, Grieco CA, Kaffenberger BH. Pasteurella multocida ecthyma complicated by necrotizing fasciitis. Dermatol Online J. 2017;23(4):13030/qt1h02t0tc.